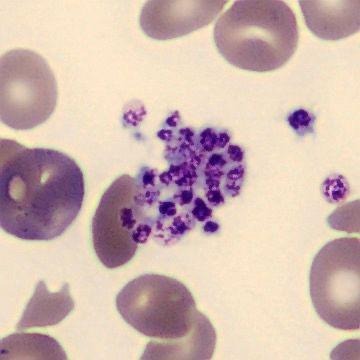

Diferenças entre pseudoplaquetopenia e plaquetopenia verdadeira
A pseudotrombocitopenia ou pseudoplaquetopenia é uma condição artefatual, caracterizada por uma contagem falsamente baixa de plaquetas em amostras de sangue coletadas em tubos contendo EDTA como anticoagulante. Esse fenômeno ocorre devido à agregação plaquetária in vitro, que faz com que o analisador automático interprete grupos de plaquetas como se fossem menos unidades individuais.

Por que o EDTA causa a Pseusoplaquetopenia?
O EDTA pode induzir agregação plaquetária in vitro por meio de autoanticorpos (IgG, IgA ou IgM) que reconhecem e se ligam a epítopos da glicoproteína IIb/IIIa na membrana das plaquetas, dessa forma, resulta em formação de grumos que reduzem falsamente a contagem de plaquetas por contadores automáticos.
Como diferenciar pseudoplaquetopenia de plaquetopenia verdadeira:
- Analise a lâmina de sangue periférico:
- Se houver montes de plaquetas agrupadas, especialmente na borda da lâmina: pense em pseudoplaquetopenia.
- Se as plaquetas estiverem diminuídas de forma difusa, bem como sem agregação: sugere plaquetopenia verdadeira.
- Repita a coleta usando outro anticoagulante
O teste confirmatório clássico:
- Tubo com citrato de sódio
- Em alguns casos, tubo com heparina
Se a contagem normaliza → pseudoplaquetopenia confirmada.
Se permanece baixa → investigar plaquetopenia verdadeira.
Avalie o contexto clínico na suspeita de pseudoplaquetopenia.
Ao avaliar um caso de possível pseudoplaquetopenia, o contexto clínico é fundamental, pois a condição não produz nenhum sinal ou sintoma no paciente. Por outro lado, as plaquetopenias verdadeiras geralmente vêm acompanhadas de manifestações como petéquias, equimoses, sangramentos mucosos, além de possíveis alterações associadas, como anemia ou leucopenia, especialmente em quadros infecciosos, autoimunes ou hematológicos.
Por que é essencial reconhecer a pseudoplaquetopenia?
Porque evita, em primeiro lugar, gerar alarme desnecessário para o paciente; além disso, impede a solicitação de exames repetidos, evitando custos e retrabalho; também previne investigações hematológicas extensas e caras quando não são necessárias; e por fim, reduz significativamente o risco de condutas equivocadas, como transfundir plaquetas sem indicação real.
Por que dominar pseudoplaquetopenia transforma sua prática?
A distinção entre pseudoplaquetopenia e uma plaquetopenia verdadeira é uma das habilidades mais importantes na rotina hematológica, pois evita erros diagnósticos, condutas desnecessárias e garante segurança ao paciente. O reconhecimento de artefatos, a análise morfológica e a interpretação integrada do contexto clínico são competências essenciais para qualquer profissional que deseja atuar com excelência no laboratório. Além disso, dominar esses temas é parte fundamental da formação em hematologia moderna.
O próximo passo de todo analista que deseja ter mais segurança na bancada
Todo analista que busca se destacar e se tornar um profissional mais atualizado, capacitado e qualificado para o mercado de trabalho precisa considerar uma pós-graduação.
Um profissional com especialização é valorizado na área laboratorial; esse é um fato inegável.
Unimos o útil ao agradável ao desenvolver uma pós-graduação em Hematologia Laboratorial e Clínica.
Para aqueles que procuram a comodidade de uma pós-graduação 100% online e ao vivo, sem abrir mão da excelência no ensino, temos a solução ideal.
Nossa metodologia combina teoria e prática da rotina laboratorial, garantindo um aprendizado efetivo.
Contamos com um corpo docente altamente qualificado, com os melhores professores do Brasil, referências em suas áreas de atuação.
No Instituto Nacional de Medicina Laboratorial, temos apenas um objetivo: mais do que ensinar, vamos tornar VOCÊ uma referência.
Toque no botão abaixo e conheça a pós-graduação em Hematologia Laboratorial e Clínica.



